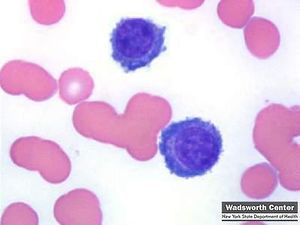

فرط الگلوبولين الضخم لوالدنستروم
| فرط الگلوبولين الضخم لوالدنستروم | |
|---|---|
| |
| گـلوبولينات ضـخمة في داء والدنستروم | |
| التبويب والمصادر الخارجية | |
| ICD-10 | C88.0 |
| ICD-9-CM | 273.3 |
| ICD-O | M9761/3 |
| OMIM | 153600 |
| DiseasesDB | 14030 |
| MedlinePlus | 000588 |
| eMedicine | med/2395 |
| MeSH | D008258 |
فرط الگـلوبولين الضـخم لوالدنستروم "Waldenström's macroglobulinemia" ويسمـى ايضا داء والـدنـسـتـروم " Waldenstrom ". وهو مرض نادر التصادف في السريريات، ويصيب المسنين من الناس، وأكثر ما تشاهد اصاباته بين الـ 50 - 70 من العمر. وسببه الرئيس فرط افراز الكلوبولينات المناعية ذات الوزن الجزيئي الكبير.
الأعراض السريرية
تلخص الأعراض السريرية كلها بعاملين:
العامل الأول
فرط نشاط وتكاثر في خلايا الجملة اللمفية الشبكية، وينتج من ذلك تثبّط النخاع وضخامة الطحال والكبد و العقد اللمفية.
العامل الثاني
ارتفاع نسبة الكلوبولينات الضخمة من نوع IgM في مصل المريض، وبما ان الوزن الجزيئي لهذه الكلوبولينات كبير ويقرب من المليون، والأضداد الباردة نوع منها، فان زيادة هذه الكلوبولينات في المصل تؤدي الى رفع لزوجة الدم وبطء سيره في العروق الدموية والشعيرات، ولهذا السبب تكثر الخثارات في هذا المرض. وبارتفاع لزوجة الدم ايضا بالاضافة الى وجود الاضداد الباردة في المصل يشكو المريض من أعراض تناذر رينو Raynaud's Syndrome ومن التحسس للبرد والحكة الشتوية والانسدادات الوعائية ونقص في الرؤيا. وبما ان الكلوبولينات IgM تؤثر سوءا في غشاء الكرية الحمراء وفي جدران الاوعية الدموية، وبما انها تستطيع الانحاد مع بروتينات المصل السوية - ومنها عوامل تخثر الدم - تكثر المتلازمات النزفية. أما آفات العظم فلا تحدث في هذا المرض.
العلاج
معالجة عرضية
تعتمد المعالجة العرضية على نقل الدم او الكريات الحمر في حال وجود فقر الدم. واذا كانت لزوجة الدم عالية جدا يلجأ الى طريقة فصل البلازما الذاتية (Plasmapheresis) التي تتم بسحب مقدار من الدم من وريد المريض ثم تثفيله وازالة البلازما عنه ثم اعادة الكريات الحمر للمريض، وتتم هذه العملية بواسطة اجهزة خاصة من البلاستيك. هذا وتعطى مركبات قشر الكظر اذا حدثت النزوف الشعرية او اصيب المريض بفقر دم انحلالي مكتسب.
المعالجة الكيميائية
تتم بإعطاء اللوكيران الذي يفيد فائدة جيدة وبه تتحسن الاعراض الشخصية والمرئية. يعطى الدواء في البدء بمقادير كبيرة، وبمعدل 6 - 10 ملغ في اليوم حسب وزن المريض مدة بضعة ايام، ثم يثابر على اعطاء الدواء في الايام التالية بمعدل وسطي يتراوح بين 2 - 4 ملغ في اليوم. هذا ويمكن ان يعطى الـ (Alheran) بطريقة مماثلة للسابقة.
اما تظاهرات فرط اللزوجة فتعالج بفصل البلازما الذاتية كما سبق ذكره بمعدل وحدتين الى اربع وحدات كل اسبوع ريثما يتم تأثير الأدوية الألكيلية في انقاص انتاج البروتينات الشاذة.
انظر أيضاً
المصادر
وصلات خارجية
- The Bing Center for Waldenström's Research
- The International Workshops on Waldenström's Macroglobulinemia
- Official website of Dr. Steven P. Treon
- The International Waldenström's Macroglobulinemia Foundation site
- National Cancer Institute's Waldenström's Macroglobulinemia Q&A
- American Cancer Society Detailed Guide: Waldenström's Macroglobulinemia
- Research Fund for Waldenström's